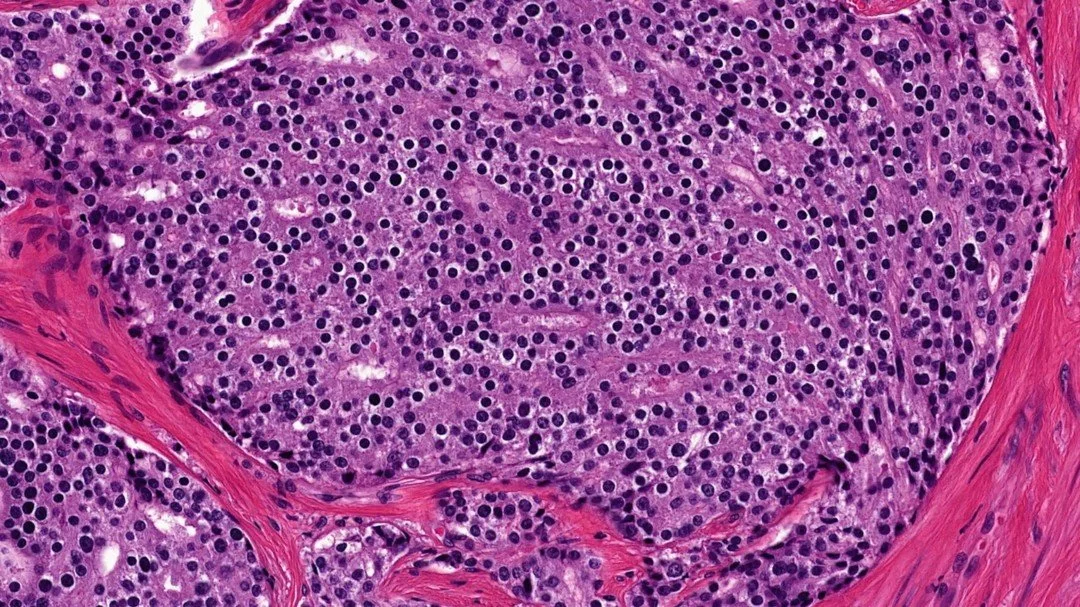

Dedicated to Improving Cancer Imaging and Patient Outcomes
About Us
Our lab at the Medical College of Wisconsin focuses on developing and validating advanced imaging techniques to improve the diagnosis, characterization, and treatment planning for brain and prostate cancers. Our research aims to bridge the gap between radiological imaging and pathological findings through radio-pathomic mapping, potentially improving clinical decision-making and patient outcomes in brain and prostate cancers through more accurate, non-invasive tumor characterization.
Key areas of our research include:
Developing radio-pathomic maps that correlate MRI features with histological features in both brain and prostate cancers, allowing for non-invasive prediction of tumor characteristics.
Validating MRI biomarkers through precise correlation with ex-vivo histology.
Investigating tumor invasion patterns beyond conventional MRI-defined margins.
Creating and validating imaging biomarkers to differentiate aggressive disease and predict patient recurrence.
Developing machine and deep learning models to analyze MRI data for improved cancer detection and characterization.
Collaborating in multi-site studies to validate quantitative imaging metrics across institutions.
What is Radio-Pathomic Mapping?
Radio-pathomic mapping is an emerging field in medical imaging that combines radiomics and pathomics to create a more comprehensive understanding of diseases, particularly in cancer research and diagnosis. The goal of radio-pathomic mapping is to improve disease diagnosis and prognosis, enhance treatment planning and monitoring, provide more personalized medicine approaches, and identify new biomarkers for diseases. This technique is particularly promising in oncology, where it can help characterize tumors more comprehensively, potentially leading to better treatment strategies and outcomes.
In our lab, we combine multi-parametric magnetic resonance imaging (MP-MRI) with digitized histological samples to create these radio-pathomic maps (RPMs). Clinical imaging and treatment history is acquired from patients who are consented to our studies. For our brain cancer tumor probability maps (TPMs), pre- and post-contrast T1-weighted images, FLAIR, and ADC are combined with large format samples taken at autopsy to detect tumor outside of contrast enhancement. For our prostate cancer radio-pathomic maps, T2-weighted images and ADC are combined with histo-morphometric features calculated from whole-mount prostate samples taken following radical prostatectomy. These maps give us a unique insights into the underlying pathology non-invasively.
Check out our online digital pathology and radiology data repositories, OMERO and XNAT